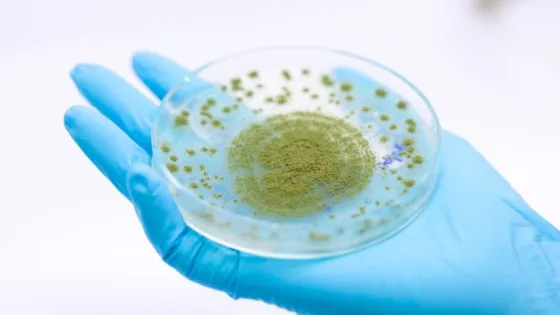
3q6s-large

- Сибирские ученые разработали эффективный способ получения поли(А)-полимеразы из кишечной палочки.
- Фермент необходим для исследования работы генов и создания мРНК-вакцин.
- Вакцины на основе мРНК являются гибким инструментом в борьбе с вирусами, бактериями и онкологическими заболеваниями.
- Преимущества мРНК-вакцин - высокая скорость и простота разработки.
- Полиаденильные хвосты на концах мРНК повышают стабильность молекул и необходимы для эффективной работы вакцин.
- Синтез полиаденильных хвостов осуществляется с помощью поли(А)-полимеразы, получаемой из кишечной палочки.
- Рекомбинантная поли(А)-полимераза из E. coli токсична для клеток и нарабатывается в нерастворимом виде.
- Штамм BL21 (DE3) pLysS показал наилучший баланс между плотностью культуры, растворимостью и активностью поли(А)-полимеразы.
- Оптимизация условий наработки поли(А)-полимеразы облегчит фундаментальные исследования и производство мРНК-вакцин.
Сибирские ученые упростили выработку фермента, необходимого для разработки РНК-вакцин
8 июл 2025
Краткий пересказ
от нейросети YandexGPT
Источник:
scientificrussia.ru
Обложка: Изображение из статьи